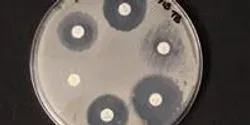

All by Northwestern University
Filter by
AllArticlesAudioEbooksEventsInfographicsNewsProductsSurveysDocumentsVideosVirtual EventsWebinars
Genetic evidence shows bacteria on the International Space Station are adapting to survive, not to harm
| 2 min read